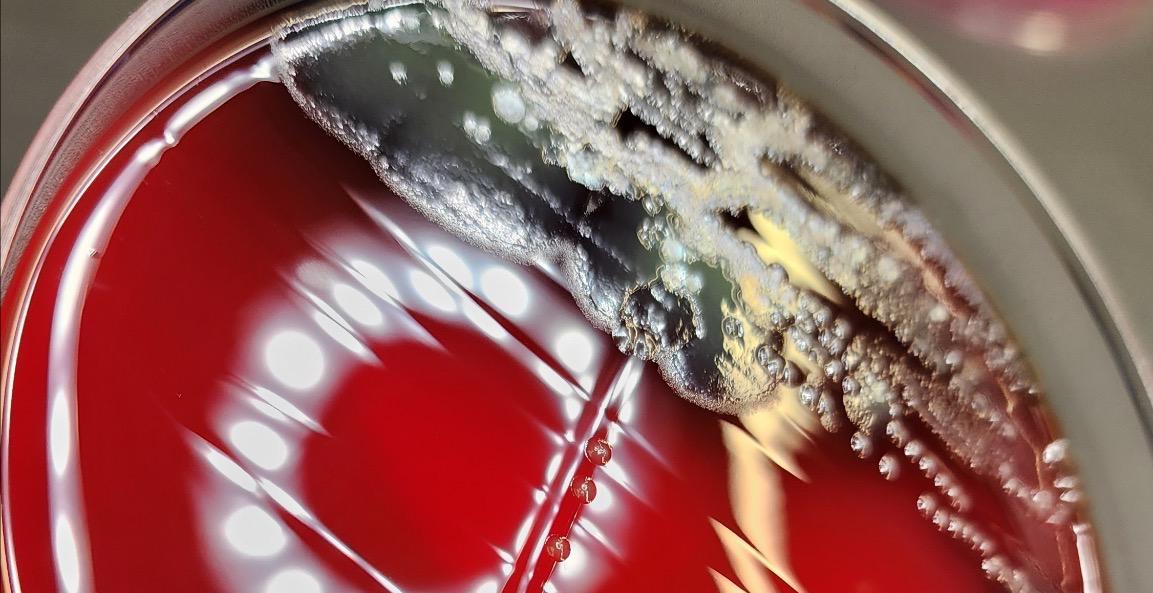
Microbiology Flow Charts

How To Effectively Study & Pass The ASCP Exam🧪
This is how to effectively study for and PASS the ASCP (or AMT) exam.
This isn’t a textbook. This is a strategy guide for students who are overwhelmed/burnt out, tired of studying with no structure or results, and/or your program never taught you how to study for the most important exam of your career.
Let’s stop guessing and start intentionally studying because you don’t need to keep rereading those old notes, you honestly just need a plan. 🫶🏽📚
0%

Inner Circle of Microscope Views 🤩
Ready to pass the ASCP with real support? Join the Inner Circle of the Microscope Views community for weekly live study sessions, full access to all replays, and hands-on help with the toughest topics.
Click here to join! ⬇️
[https://www.skool.com/microscopeviews/about?ref=badbb26c40a147eea94634972a25414a](https://www.skool.com/microscopeviews/about?ref=badbb26c40a147eea94634972a25414a)
0%
Microbiology
Microbiology Gram Positive and Gram Negative flow charts
0%

Metabolic Syndrome & Lipid Breakdown 🍔🍩
Metabolic Syndrome is one of the most high-yield topics in the Chemistry section of the ASCP, and if you don’t understand how lipids, hormones, and calculations tie into each other… this is where that ends.
0%

Unlock for $10
Bacteriology Buzzwords 🐝🦠🧫
If you’ve ever sat there staring at a question like “non-lactose fermenting, oxidase positive, curved rod…”and your brain just goes blank… like me during our study sessions... yeah, we’re done with that NEEEEEEOW!
I just organized a FULL Bacteriology Buzzword Master Sheet that breaks down the organisms you’re MOST likely to see on the ASCP and grouped in a way that makes sense!
ASCP doesn’t care if you “kinda remember” facts. They want to know if you can IDENTIFY the organism with confidence.
0%

Unlock for $10
Ultimate Parasitology Guide
Inside is the complete PDF of every major PARASITE you need to know for the ASCP exam with:
🔬 Clear photos
📝 Descriptions of each organism
📏 Sizes
💀 Diseases they cause
🦟 Vectors & transmission details
0%
1-6 of 6